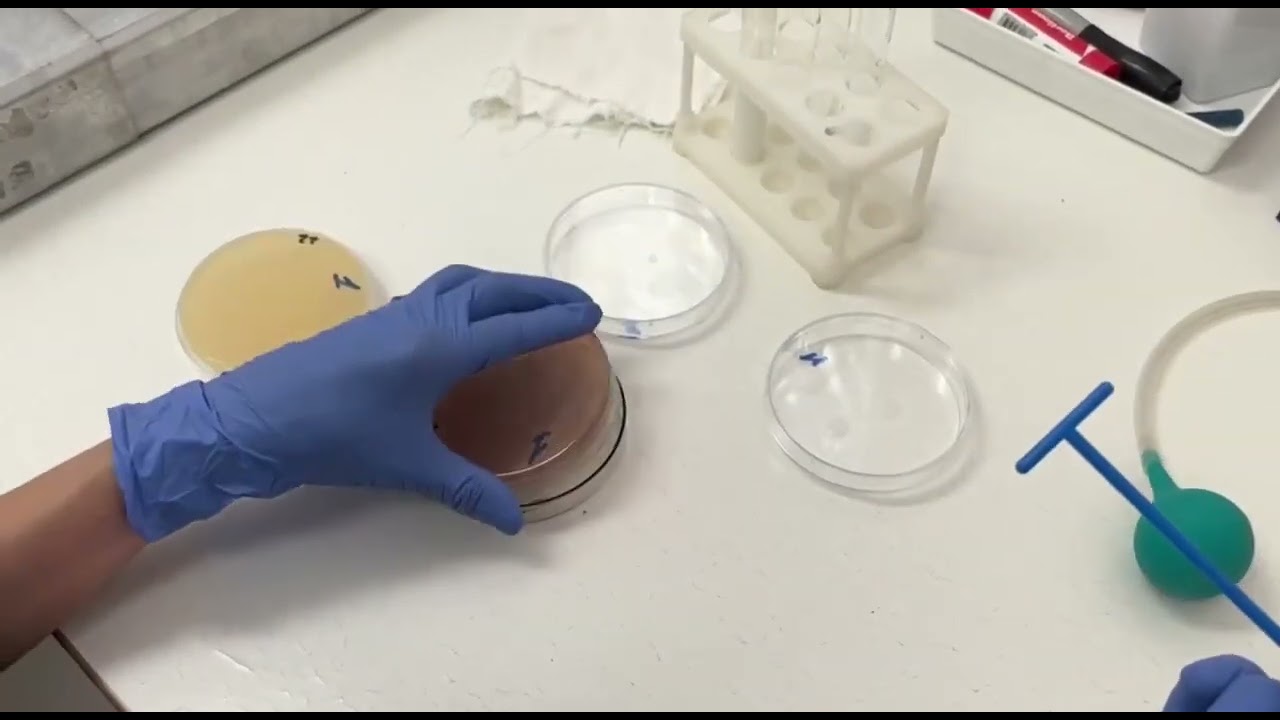

Бактерии-вредители продуктов питания
Бактерий, приносящих пользу и так необходимых человеку для существования, много, но не меньшее количество и вредителей, вызывающих порчу продуктов. Многие продукты, в которых живут такие бактерии, становятся опасными для здоровья и источником таких страшных заболеваний, как:
- сальмонеллез;
- холера;
- токсикоинфекция;
- дизентерия;
- ботулизм;
- брюшной тиф.
Под воздействием маслянокислых бактерий происходит порча сыров и молочных продуктов. Появляется горький привкус и неприятный запах. Маслянокислые микробы приводят к порче масла сливочного, семян подсолнечника, сои, зерна и делают их непригодными для питания.
Уксусные бактерии (уксуснокислые) своей деятельностью вызывают прокисание винной продукции.
Микрококки выделяют ферменты, которые расщепляют белки, тем самым вызывая гниение продуктов, и отсюда резкий неприятный запах.
Сальмонелла, чаще всего проникая через поры яичной скорлупы, приводит к порче яиц и серьезному заболеванию сальмонеллезу.
Палочки перфрингенс и ботулиновые без доступа кислорода (чаще это консервы) начинают размножаться и выделяют ядовитые токсины, что при несвоевременной госпитализации зачастую заканчивается летальным исходом для человека.
Молочнокислые бактерии часто поражают муку. Бациллы приводят к порче уже готового хлеба, расщепляя хлебный крахмал, углеводы и делая хлебный мякиш липким, тягучим и с неприятным запахом.
Врачи отмечают, что исследование кисломолочных продуктов на наличие живых бактерий имеет важное значение для оценки их полезных свойств. Кисломолочные продукты, такие как йогурты и кефир, известны своим положительным влиянием на здоровье кишечника благодаря пробиотикам. Специалисты подчеркивают, что наличие живых бактерий в этих продуктах способствует улучшению пищеварения и укреплению иммунной системы.
Однако, врачи также предупреждают о необходимости тщательного контроля качества таких продуктов, так как не все производители соблюдают необходимые стандарты. Важно, чтобы исследования проводились с использованием современных методов, что позволит точно определить количество и вид живых бактерий. В целом, результаты подобных исследований могут помочь потребителям делать более осознанный выбор и способствовать популяризации здорового питания.

Микроорганизмы, приносящие пользу
Для поддержания нормальной микрофлоры кишечника человека современная наука предоставила пищевой промышленности информацию о технологиях производства продуктов питания. Благодаря им полезные бактерии могут держать под контролем иммунитет человека, а также деятельность патогенных и условно патогенных бактерий.
Такой контроль в основном является результатом работы лактобактерий и бифидобактерий.
Лактобактерии – анаэробные бактерии, которые населяют ротовую полость, желудок, тонкий и толстый кишечник. Лактобактерия в организме человека является производителем молочной кислоты, веществ, обладающих антибиотическими свойствами, перекиси водорода и т.д.
Заселяя лактобактерию в молоко, производители в пищевой промышленности добиваются того, что в кисломолочных продуктах повышается количество нужных бактерий, которые должны присутствовать в пище человека.
Бифидобактерии – анаэробные бактерии, которые составляют естественную среду кишечника человека. Их полезные качества заключаются в поддержании иммунитета, а также в синтезе витаминов группы В и группы К.
В пищевой промышленности бифидобактерии чаще всего используют во время производства кисломолочных продуктов на базе кефира. В таких продуктах нуждаются и дети, и старики, и взрослые, поскольку больше ни в какой другой пище невозможно найти такую мощную поддержку для иммунной системы. Кроме содержания в кисломолочных продуктах питания, бифидобактерия входит только в состав лекарственных препаратов.
Алкоголь
Говоря о веществах, которые медленно, но уверенно разрушают наш организм, нельзя не сказать об алкогольных напитках.
Сразу хотелось бы отметить, что алкоголь в малых количествах не только не вреден для здоровья, а и полезен, поскольку способствует снижению холестерина, предупреждает образование тромбов, расширяет сосуды, а также усиливает кровообращение. В итоге снижается риск развития сердечно-сосудистых болезней. При этом предпочтение желательно отдавать красному вину, дневная норма которого составляет не больше двух стаканов.
А вот чрезмерное употребление алкоголя (включая пиво, ликеры и вермуты) приводит к нарушению работы организма в целом, ведь алкоголь не действует избирательно, он повреждает организм практически мгновенно, причем по всем направлениям сразу.
В то время, когда печень пытается справиться с этанолом, часть уже всосавшегося алкоголя негативно воздействует на функции головного мозга, а также сердечно-сосудистой системы. Но и это еще не все: в то же время нарушается функционирование желудка, поджелудочной, а также кишечника. Зачастую комплекс повреждающих факторов настолько обширен, что может спровоцировать сильнейшую алкогольную интоксикацию, которая приводит к смерти либо тяжелой инвалидизации.
Хотелось развенчать несколько мифов об алкоголе.
Алкоголь помогает согреться
Чтобы согреться, достаточно выпить 50 г водки либо коньяка (как известно, алкоголь расширяет сосуды и нормализует кровоснабжение внутренних органов). А вот последующие дозы усилят кровоток только в коже, отчего она покраснеет и появится приятное ощущение тепла. Но такое ощущение быстро пропадет, поскольку с последующими дозами алкоголя усилится и теплоотдача, то есть организм остынет еще быстрее.
Алкоголь способствует повышению аппетита
И это так, причем для возбуждения аппетита достаточно всего лишь 25 г крепкого алкогольного напитка. При этом пьется спиртное за полчаса – час до еды.
Алкоголь эффективно борется со стрессом
Алкоголь помогает расслабиться после тяжелой трудовой недели, но для такого расслабления достаточно 50 мл коньяка или бокала вина. Но после первых 50 мл настроение улучшается, хочется продолжения «банкета». В итоге становится еще грустнее, а непродолжительное ощущение праздника и эйфории сменяется ощущением безысходности.
Алкоголь способствует снижению артериального давления
Небольшая доза спиртного (например, 100 мл сухого красного вина) действительно способна ослабить тонус сосудистой стенки, но при этом алкоголь увеличивает частоту сердцебиения. В итоге: чем больше выпито, тем выше давление.
Качественный алкоголь не вредит здоровью
Любой без исключения алкогольный напиток отравляет организм. Вопрос лишь в том, что дешевое спиртное не проходит должной степени очистки, поэтому содержит так называемые сивушные масла, многократно усиливающие токсическое действие алкоголя.
Пиво не является алкоголем
Это утверждение не имеет права на существование, поскольку пиво (хоть и в небольшом количестве) содержит спирт.
Алкоголь не содержит калорий
Содержит, причем очень большое количество. И чем крепче напиток, тем он калорийнее.
Алкоголь не запивается, а закусывается
Многие придерживаются того мнения, что алкоголь следует именно закусывать, даже не подозревая о том, что закуска закуске рознь. Так, холодные закуски (как и соки, морсы и компоты) очень плохо нейтрализуют спирт, который быстро всасывается в кровь. А вот горячие и жирные блюда, напротив, подавляют всасывание этанола, тем самым уменьшая выраженность опьянения. Поэтому закусывать лучше горячими закусками.
В каких продуктах содержится спирт?
Интересный факт! Слово «алкоголь» ассоциируется у нас с жидкостью, полученной путем брожения. Но существуют продукты, в которых алкоголь присутствует в виде фруктозы, которая непосредственно в организме вступает в процесс брожения, тем самым образуя алкоголь в крови.
Продукты и напитки, содержащие алкоголь (спирт):
- все алкогольные и слабоалкогольные напитки;
- квас;
- кумыс (восточный напиток);
- кефир;
- йогурт;
- простокваша;
- фруктовые соки (дело в том, что при изготовлении соков часто применяют специальный концентрат, основой которого является спирт);
- шоколад;
- леденцы;
- пирожные;
- бананы (особенно перезревшие);
- кислая капуста;
- яблоки;
- виноград;
- сыр;
- цитрусовые;
- сметана;
- черный хлеб.
Презентация работы, посвященной исследованию кисломолочных продуктов на наличие живых бактерий, вызвала живой интерес среди слушателей. Многие отметили актуальность темы, особенно в свете растущего интереса к здоровому питанию и пробиотикам. Участники обсуждали важность живых бактерий для пищеварения и иммунной системы, а также их влияние на общее состояние здоровья. Некоторые задавали вопросы о методах исследования и полученных результатах, выражая желание узнать больше о конкретных продуктах. В целом, презентация способствовала активному обмену мнениями и углубленному пониманию роли кисломолочных продуктов в рационе. Люди выразили надежду на дальнейшие исследования в этой области и возможность применения полученных данных в практике.

Кто живет в кисломолочной среде
В последние годы современные технологии позволили внедрять молочнокислые бактерии в продукты питания, создавая новую продукцию. В зависимости от вида микроорганизмов, используемых при заквасках, выходят разные виды молочнокислых изделий.
Лактобактерии
Этот вид бактерий является самым разнообразным. Они являются нашими естественными обитателями и заселяются в кишечник человека с первых дней рождения вместе с материнским молоком. Лактобактерии вырабатывают лактазу – фермент, расщепляющий молочные углеводы, при этом образовывается молочная кислота, подавляющая жизнедеятельность болезнетворных бактерий.
Lactococcus lactis
Ацидофильная палочка
Lactobacillus acidophilus известна не только в пищевой промышленности, но и в медицине. Ее применяют в лечении многих кишечных заболеваний не только у взрослых, но и у младенцев. Эта палочка является самым сильным кислотообразователем, попадая в кишечник, она прекрасно приживается и вырабатывает естественные антибиотики, создавая тем самым невозможную для жизни патогенных бактерий среду. Благодаря ее высокой жизнестойкости и способности оберегать микрофлору кишечника ее применяют при химиотерапии и приеме антибиотиков.
Болгарская палочка
Lactobacillus bulgaricus по-другому называют болгарским йогуртом. Впервые была выявлена И. И. Мечниковым, который ввел ее в свой постоянный рацион. В процессе жизнедеятельности болгарская палочка подавляет болезнетворные бактерии, что связано с ее способностью вырабатывать молочную кислоту при сбраживании углеводов и лактозы. Этот вид бактерий имеет еще и такие достоинства:
- выработка витаминов и биологически активных веществ, микроэлементов, аминокислот, полисахаридов;
- улучшение качества йогурта.
Продукты, в которых содержится болгарская палочка, способствуют стабилизации микрофлоры, нормализуют работу желудка и кишечника, обладают слабительным действием, улучшают работу поджелудочной железы, повышают иммунную систему.
Lactobacillus casei
Этот вид бактерий встречается в ротовой полости, кишечнике и влагалище. Данную лактобактерию активно используют в производстве питьевых йогуртов с целью повышения сопротивляемости организма. Lactobacillus casei в борьбе за среду существования вытесняет Helicobacter pylori, которая является возбудителем гастритов, язв и других заболеваний желудка.
Термофильный стрептококк
Streptococcus thermophilus широко применяется в пищевой промышленности для изготовления молочнокислых изделий и сыров, к примеру, моцареллы. Данный микроорганизм обладает способностью в короткие сроки повышать кислотность молока, что является одним из условий при приготовлении многих видов изделий. Полисахариды, синтезируемые этим микроорганизмом, дают равномерную плотную массу с высокими вкусовыми качествами и приятным запахом. Результат работы бактерий – это связывающая способность, замедляющая процесс расслаивания. Это позволяет в производстве обходиться без каких-либо специальных загустителей и стабилизаторов. Эти бактерии очень чувствительны к антибиотикам, и часто это свойство применяют для определения порчи молока, то есть не добавлен ли в него пенициллин.
Бифидобактерии
Bifidobacterium ─ жители кишечника человека. В кишечнике младенца их находится до 80%. Эти полезные бактерии вырастить самостоятельно сложно. Их выращивают в специальных лабораториях. На упаковках продуктов, в составе которых есть бифидобактерии, всегда стоит приставка «био».
Уксуснокислые бактерии
Acetobacter aceti являются обязательными составляющими среды обитания кефирных грибков, которые производят никотиновую кислоту, витамин В12 и рибофлавин, которые, как и углеводы, необходимы человеку.
Пробиотики
Пробиотики представляют собой полезные для здоровья человека микроорганизмы. К пробиотикам причисляют живые микроорганизмы (а именно молочнокислые бактерии, бифидобактерии и дрожжи), присутствующие в кишечнике здорового человека.
В норме в организме человека должно присутствовать порядка 1 – 1,5 кг пробиотиков (именно такое их количество обеспечивает полноценную работу не только систем и органов, а и иммунной системы). Но реалии далеки от нормы: так, на деле в организме человека присутствует около одной десятой от установленной нормы пробиотиков, тогда как у многих людей почти вся здоровая микрофлора и вовсе замещена патогенной.
Польза пробиотиков
- Укрепление иммунитета.
- Синтез витаминов К и В.
- Улучшение пищеварения.
- Нейтрализация токсинов и патогенных бактерий.
- Нейтрализация вредного воздействия на организм антибиотиков.
- Устранение и лечение диареи.
- Уменьшение проявлений аллергии.
- Устранение воспалений.
- Поддержание в норме метаболизма.
- Борьба с инфекциями.
- Улучшение состояния кожных покровов.
В каких продуктах содержатся пробиотики?
Один из основных источников пробиотиков – йогурт, который поможет справиться с диареей, метеоризмом, а также иными нарушениями пищеварения.
Помимо йогурта, пробиотики присутствуют в таких продуктах:
- сыры мягких сортов;
- кефир;
- простокваша;
- ряженка;
- творог;
- мисо-суп (мисо является ферментированным продуктом из соевых бобов);
- тофу (или соевый сыр);
- квашеная капуста;
- соленые огурцы и помидоры;
- хлеб на закваске;
- артишоки;
- репчатый лук;
- моченые яблоки;
- лук-порей;
- банан.
Важно! Эффективность пробиотиков значительно возрастает при одновременном употреблении их с пребиотиками, которые не перевариваются в кишечнике, однако создают благоприятную среду как для роста, так и для жизнедеятельности здоровой кишечной микрофлоры
Бактериальное сотрудничество
Живые кисломолочные бактерии во все времена помогали человеку в изготовлении вкусной и полезной пищи:
- Различные виды лактобацилл и стрептококков содержатся в кисломолочных продуктах. Именно их чаще всего запечатлевают на фото, так как они крупные и встречаются довольно часто.
- Лактобациллы плантарум (Lactobacillus plantarum) сквашивают капусту и огурцы. Тоже на фото выглядят как толстенькие палочки. Квашеные овощи содержат продукты кисломолочного брожения, которые полезны для организма человека. Лактобациллы плантарум входят в состав естественной микрофлоры кишечника, а также в состав слюны человека.
- Кислое тесто для выпечки хлеба производят живые кисломолочные бактерии, которые сбраживают продукты, входящие в состав теста, в результате чего хлеб приобретает кисловатый привкус.
- В современном промышленном производстве также используют молочную кислоту, которую вырабатывают живые кисломолочные бактерии:
- Обрабатывая молочной кислотой сырокопченые колбасные продукты, производители тем самым предотвращают их порчу. При этом сами продукты остаются полезными для организма человека и не теряют своих вкусовых качеств.
- С использованием молочной кислоты обрабатываются кожевенные заготовки.
- Кисломолочные бактерии принимают участие в производстве силоса для домашних животных.
Виды молочнокислых бактерий
Молочнокислые бактерии — в молочных продуктах
Группа микроорганизмов, производящих молочную кислоту из разлагаемых углеводов, довольно многочисленна и разнообразна.
Можно выделить основные виды молочнокислых бактерий, которые наиболее распространены и играют важную роль в пищеварении:
- Болгарская палочка – выделена из болгарского кислого молока. Она не отличается подвижностью и не образует споры. Длина одной бактерии достигает 20 мкм, часто они образуют короткие цепочки. Болгарская палочка активизируется при температуре свыше 40°С, очень быстро свертывает молоко с высокой концентрацией молочной кислоты (до 32 г/л).
- Молочнокислый стрептококк – обнаружен в большинстве молочных продуктов. Он не образует спор и соединяется попарно. Оптимальная температура развития – около +30°С. При заражении стрептококком молоко свертывается в течение 12 ч. Бактерия способна противостоять размножению патогенной грибковой микрофлоры.
- Лактококк – в первое время после образования имеет вид стрептококка. Он не образует спор и не обладает подвижностью. Лактококк развивается при температуре около +30°С, молоко сбраживает в течение 25 ч. Содержание молочной кислоты при этом не превышает 7 г/л, так как в при более высокой кислотности бактерия становится нежизнеспособной.
- Ацидофильная палочка – впервые была выделена из детских фекалий. Она развивается при температуре около +40°С и обладает антибактериальными свойствами. Содержание молочной кислоты в результате сбраживания этим микроорганизмом достигает 2-3 г/л.
- Сливочный стрептококк – лучше всего растет при 25°С, но жизнеспособен и при более низких температурах (начиная от +10°С). Бактерия образует длинные цепочки.
В зависимости от вида лактобациллы при развитии в питательных средах образуют колонии, отличающиеся внешним видом:
- росинчатые;
- в виде лодочек;
- шероховатые;
- паучковидные;
- комковатые;
- слизистые;
- звездчатые.
Из всего разнообразия молочнокислых бактерий в отдельную группу выделяют патогенные микроорганизмы (в том числе пневмококки) и рассматривают их вне этой классификации.
Часть спорообразующих аэробных микроорганизмов, наоборот, причисляют к молочнокислым (бифидобактерии, инулиновые споролактобактерии) в связи с похожими функциями и метаболизмом.
Пищевые волокна с пребиотиками
Важная составляющая растительных пищевых продуктов, которая не переваривается ферментами ЖКТ – это пищевые волокна с пребиотиками. Они благоприятно воздействуют на общее состояние организма, предупреждают различные заболевания и выступают частью диетической терапии. Самые популярные волокна – это клетчатка и пектин, они являются сложными углеводами, которые состоят из полисахаридных цепочек. Они водорастворимые и обладают высокой гигроскопичностью, способны связывать большое количество воды, набухая и увеличиваясь в 50 раз. Это усиливает перистальтику кишечника и увеличивается частоту и объем стула.
Выделяют два вида пищевых волокон:
- Нерастворимые – это целлюлоза и лигнин. Они набухают в воде, увеличивая массу и частоту стула, предотвращают запоры, воспаления кишечника, геморрой.
- Растворимые – набухают в воде и образуют клееподобный гель. Полученное вещество состоит из нецеллюлозных углеводов, пектинов, полисахаридов и гемицеллюлозы.
Пищевые волокна поддерживают нормальное состояние пищеварительного тракта, очищают его, снижая риск онкологии толстой кишки. Способствуют росту дружественной микрофлоры кишечника, особенно Lactobacillus и Bifidobacter.
[], [], [], [], [], [], [], [], [], []
Афродизиаки
Афродизиаками называются вещества, увеличивающие жизненные силы в целом и половое влечение в частности. Свое название они получили в честь греческой богини красоты и любви Афродиты. Да и само слово «афродизиак» переводится с греческого как «любовное наслаждение».
Афродизиаки не только повышают потенцию, а и способствуют устранению фригидности, они предотвращают преждевременное семяизвержение, а также увеличивают продолжительность полового акта.
В чем же секрет любовных свойств афродизиаков?
Во-первых, большая часть афродизиаков имеет высокую пищевую ценность и содержит множество витаминов и микроэлементов, а это способствует не только правильному обмену веществ, но и быстрому восстановлению сил.
Во-вторых, в некоторых афродизиаках присутствуют ферменты, которые по своим свойствам схожи с половыми гормонами человека (есть афродизиаки, содержащие вещества, способствующие выработке половых гормонов самим организмом).
В-третьих, натуральные афродизиаки усиливают образование эндорфинов (гормонов счастья), которые, как известно, обостряют сексуальное желание, усиливают эротические фантазии, делают человека раскрепощенным и счастливым.
В каких продуктах содержатся афродизиаки?
Креветки, устрицы, икра
Содержат большое количество белка, придающего сил, и цинка, участвующего в синтезе тестостерона.
Авокадо
Этот фрукт содержит множество витаминов и природные гормоны, способствующие повышению потенции, прежде всего, у мужчин.
Орехи
Насыщают организм, не отягощая при этом желудок, поэтому энергия будет расходоваться на получение удовольствия от любовных услад, а не на процесс переваривания пищи.
Шоколад
Черный шоколад является лучшим возбудителем для женщин, поскольку содержит кофеин и теобромин (эти вещества пробуждают эротические чувства, способствуя выработке женских гормонов). Интересно и то, что сам запах шоколада провоцирует выработку эндорфина.
Лук и чеснок
Да, да, да! Эти овощи, имеющие неприятный запах, благотворно воздействуют на либидо.
Специи
Кардамон, фенхель, укроп, анис, красный перец, карри бодрят, корица, имбирь, улучшают кровообращение, стимулируют приток крови к половым органам.
Клубника
Эта вкусная и красивая ягода содержит эндорфины, улучшающие настроение и обостряющие чувства.
Овсянка
Доказано, что овсянка способна регулировать половое влечение, тогда как у мужчин этот продукт регулирует сперматогенез и увеличивает концентрацию тестостерона в крови.
Финики
Этот плод, по праву считающийся самым сладким на планете Земля, усиливает сексуальную выносливость за счет большого содержания в нем фруктозы, глюкозы, а также углеводов.
Мед
Повышает половое желание благодаря тому, что в большом количестве содержит бор, улучшающий настроение и способствующий появлению сексуального желания.
Важно! Все продукты-афродизиаки следует употреблять в свежем виде. Они не должны подвергаться продолжительной термической обработке (желательно такие продукты не солить)
А вот употребление углеводов, алкогольных напитков, жирной и жареной пищи необходимо сократить до минимума, поскольку они подавляют сексуальное желание.
Пищевые источники афродизиаков:
- мясо дичи;
- злаки;
- бобовые;
- квашеная капуста;
- семена льна;
- гранаты;
- яблоки;
- вино;
- сельдерей;
- спаржа;
- изюм;
- бананы;
- курага;
- манго;
- дыня;
- маракуя;
- вишня;
- яйца.
Растительные афродизиаки:
Польза кисломолочных продуктов
Пользу кисломолочных продуктов трудно переоценить. Медики считают, что регулярное употребление таких компонентов в пищу снижает шансы развития заболеваний практически в два раза. Больше всего пользы эти представители здорового питания дают на пищеварительные органы. А точнее без нужных бактерий, что содержатся в таких продуктах, нормальное пищеварение обеспечить невозможно.
Кисломолочные продукты способны влиять на различные органы, их польза заключается в следующих факторах:
- Все полезные бактерии, что входят с состав очень быстро и беспроблемно усваиваются в организме;
- Бифидобактерии и лактобактерии способствуют быстрому расщеплению белков в организме;
- Молочная кислота способствует нормализации работы внутренней микрофлоры кишечника, благодаря активным компонентам гибнут вредные бактерии, и увеличивается количество полезных;
- Кисломолочные продукты наполнены жирными органическими кислотами, которые улучшают моторику пищеварительного тракта;
- Эти продукты активно борются с метеоризмом, уменьшая количество газов в кишечнике;
- Кисломолочные продукты намного полезней, чем свежее молоко, в их состав входит в десять раз больше аминокислот, нежели в свежем продукте, а эти компоненты активизируют метаболические процессы;
- Кальций укрепляет костную ткань, регулярное употребление кисломолочных продуктов – необходимая профилактика остеопороза;
- Эти продукты используются для профилактики и лечения гипертонии и атеросклероза;
- Бифидобактерии активно борются с токсинами, что выделяются при приеме вредных продуктов или под воздействием других факторов, они их не просто утилизируют, а выводят из организма вместе с тяжелыми металлами, шлаками, радионуклидами и солями;
- Кисломолочные продукты повышают аппетит, укрепляют иммунную систему человека.
Такой широкий спектр полезных свойств определяет важность этой продукции. Особенно важно вводить ее в рацион детей
Именно в детском возрасте организм формируется и ему нужны витамины и минералы, которые содержатся в кисломолочных продуктах.
Потенциальный вред и противопоказания
Кисломолочные продукты, несмотря на огромный спектр положительных эффектов, в отдельных ситуациях могут принести не только пользу, но и вред здоровью человека.
К числу побочных эффектов и противопоказаний относятся:
- Аллергические реакции. Встречаются при чувствительности организма к отдельным составным элементам кисломолочных продуктов. Аллергия может проявляться по-разному: ангионевротический отёк, анафилактический шок, крапивница, изолированный кожный зуд и т.п.
- Раздражение слизистых оболочек желудка. Наблюдается только при потреблении продуктов смешанного брожения (кефир). Этиловый спирт, при наличии недостаточности секреции желудочного сока или при активном воспалении, оказывает отрицательное влияние на слизистую оболочку желудка.
- Непереносимость лактозы. Многие молочные продукты содержат лактозу. При тяжёлой степени тяжести данного состояния возможно появления множества расстройств пищеварения: боли в животе, вздутие, диарея. Однако, если выработка лактазы в организме ещё присутствует, пробиотики помогают корректировать патологию.
- Сепсис. Нельзя употреблять кисломолочные продукты при наличии открытых раневых дефектов (эрозивный гастрит, язвенная болезнь желудка и двенадцатиперстной кишки, неспецифический язвенный колит тяжёлой степени тяжести). В сочетании со снижением иммунитета (при длительном лечении глюкокортикостероидами или антибиотиками, на фоне ВИЧ-инфекции) это может привести к проникновению микроорганизмов в системный кровоток и вызвать ряд септических осложнений.
В отдельных случаях кисломолочные продукты могут быть вредны для организма. Необходимо учитывать весь спектр противопоказаний и при необходимости проконсультироваться с врачом.
Значение кисломолочных продуктов в питании населения
Оздоровление организма человека и обеспечение его активной жизнедеятельности на основе массового использования кисломолочных продуктов с пробиотическими свойствами являются новым перспективным направлением в медицине и нутрициологии, как ее составной части. По данным японских исследователей, применение лакто- и бифидобактерий в составе пробиотических препаратов и в продуктах функционального питания уже в начале XXI века наполовину вытеснит существующий рынок химических лекарственных препаратов и тем самым даст возможность решить проблему здоровой микробной экологии человека .
Кисломолочные продукты содержат достаточное для полноценного питания количество незаменимых аминокислот (в ферментированном молоке содержание свободных аминокислот в 7–11 раз выше, чем в свежем), витаминов А, D, Е; солей фосфора, кальция, магния, участвующих в обмене веществ в организме человека . Молочная кислота, диоксид углерода, следы алкоголя (в кефире, кумысе) оказывают сильное стимулирующее воздействие на пищеварительные железы, что улучшает процесс переваривания и усвоения пищи. Кисломолочные продукты обогащают желудочно-кишечный тракт молочнокислыми и другими бактериями, способными существенно повышать иммунную активность организма, а некоторые также «приживаться» в кишечнике .
Следует отметить, что кальций из ферментированных молочных продуктов легче усваивается организмом человека в связи с переходом его в кислой среде в растворимое состояние и частичным высвобождением из белковых молекул за счет гидролиза белков заквасочными микроорганизмами .Регулярное потребление кальция с молочными продуктами, особенно в детском и юношеском возрасте, оказывается решающим фактором повышения прочности костной ткани и предупреждения остеопороза .
Важную роль в питании людей, страдающих лактазной недостаточностью, играет йогурт. Этот продукт, в отличие от молока, не вызывает отрицательной реакции у людей с недостатком фермента лактазы, причем данный эффект обусловлен не только присутствием в нем лактазы заквасочной микрофлоры, но и составом йогурта . Йогурты способствуют выведению из организма вредных веществ и в целом нормализации пищеварения. Эпидемиологические исследования свидетельствуют о снижении риска заболевания раком кишечника при регулярном потреблении йогуртов. Антимутагенные свойства йогурта связаны с продуктами его ферментации . Японские ученые установили, что йогурты эффективны при лечении легких случаев радиоактивного облучения. Исследования последних лет показали, что традиционные заквасочные бактерии, входящие в состав йогуртов, губят бактерии, провоцирующие язвы желудка и двенадцатиперстной кишки. Многие исследователи отмечают необходимость ежедневного употребления йогуртов для поддержания в пищеварительном тракте нормальной микрофлоры.
Кисломолочными называются продукты, вырабатываемые из пастеризованного молока и сливок путем сквашивания его заквасками, приготовленными из чистых бактериальных культур молочнокислых бактерий. Кисломолочные продукты делятся на продукты молочнокислого и смешанного брожения – молочнокислого и спиртового. К продуктам молочнокислого брожения относятся сметана, творог, ряженка, простокваша, йогурт, ацидофилин. К продуктам смешанного – кефир, кумыс, ацидофильно-дрожжевое молоко.
Кисломолочные продукты имеют большое значение в питании человека, так как они обладают диетическими и лечебными свойствами, а, кроме того, у них приятный вкус и они легко усваиваются организмом. Кисломолочные продукты нормализуют обмен веществ, укрепляют иммунитет, формируют здоровую слизистую оболочку кишечника, способствуют выведению токсичных веществ, способствуют улучшению пищеварения. Молочная кислота, присутствующая в этих продуктах, улучшает обмен веществ, усиливает перистальтику кишечника
Очень важно и то, что многие молочнокислые бактерии вырабатывают такие витамины, как В1, В2, С, и антибиотики, подавляющие развитие болезнетворных микробов. Особенность кисломолочных продуктов – это их способность улучшать флору кишечника
Как в пищу попадают болезнетворные микробы
Купленный с уличного лотка хот-дог или испорченная колбаса могут стать виновниками пищевого отравления, которое сопровождается следующими симптомами:
- рвота, тошнота;
- озноб;
- расстройство стула;
- головокружение;
- слабость;
- боли в животе.
Возбудителями таких серьезных недомоганий становятся бактерии. Они могут находиться в сыром мясе, на поверхности фруктов и овощей. Полуфабрикаты часто подвержены порче при нарушении правил хранения.
Пища может быть заражена в местах общественного питания, если работники после посещения туалета не моют руки. Блюда, выставленные на витрине, тоже рискуют «подхватить» порчу. Ведь посетители могут чихнуть или кашлянуть, выбирая себе яство.
Переносчиками болезней часто становятся грызуны, птицы, домашние животные. Соприкасаясь с человеческой пищей, они могут заразить ее.
Болезнетворные бактерии, вызывающие отравления, очень быстро размножаются на поверхности столов, разделочных досках, ножах. В процессе приготовления еды на кухонном инвентаре остаются крошки, которые являются отличной питательной средой для микробов, что вызывает порчу продуктов.
Государственные стандарты для выявления микроорганизмов и оценки качества еды
Для всех товаров, изделий, продуктов питания разработаны и созданы ГОСТы. В рамках темы, касающейся бактерий и их содержания на пищевых продуктах, можно выделить два типа стандартов:
- ГОСТы, регламентирующие необходимое число полезных микроорганизмов в молочной и кисломолочной продукции;
- нормативные акты, описывающие процедуру выявления тех или иных бактерий.
ГОСТ Р 52687 – 2006 описывает классификацию, внешний вид и условия выработки кисломолочных изделий, обогащенных бактериями бифидум: йогуртов, кефиров и кефирных продуктов (в том числе и детских). В нем же есть отсылки к методам их исследования на предмет соответствия качеству.
ГОСТ Р 52972 – 2008 создан для производителей полутвердых сыров. Документ с номером Р 52686 – 2006 описывает общие технические условия и требования безопасности сыров и сырной продукции.
Сотрудники микрохимических лабораторий работают по большому числу нормативных документов. Перечисление их всех может занять большой промежуток времени. Среди наиболее распространенных стандартов можно назвать:
- ГОСТ 52814 – 2007 о методах исследования пищевых продуктов на предмет выявления бактерий из рода Сальмонелла.
- ГОСТ 52815 – 2007 описывает методы определения числа стафилококков, которое содержится в исследуемом образце.
- ГОСТ 31747 – 2012 регламентирует методы вычисления количества бактерий кишечной группы в пищевых продуктах.
Из всего вышесказанного можно сделать вывод, что продукты питания подвергаются всестороннему и жесткому контролю на всех этапах производства. Добросовестный производитель, работающий с четким соблюдением всех норм, не допустит антисанитарии в цехах и пуска в обработку сырья, не прошедшего должный микробиологический контроль.
Со стороны потребителя требуется четко соблюдать условия хранения, обработки и приготовления пищи. Следование простым правилам личной гигиены и соблюдение чистоты на кухне позволят не допустить проникновение и рост числа бактерий (и, как следствие, отравлений) по собственной вине.
Вопрос-ответ
Каковы основные цели исследования кисломолочных продуктов?
Основные цели исследования заключаются в определении наличия живых бактерий в кисломолочных продуктах, оценке их количества и качества, а также выявлении возможных факторов, влияющих на сохранение жизнеспособности этих микроорганизмов в процессе хранения и потребления.
Какие методы использовались для анализа проб кисломолочных продуктов?
Для анализа проб использовались микробиологические методы, такие как посев на питательные среды, микроскопия и молекулярно-генетические методы, включая ПЦР (полимеразная цепная реакция), что позволяет точно определить видовой состав бактерий и их количество.
Каковы результаты исследования и их значение для потребителей?
Результаты исследования показали, что большинство образцов содержат живые пробиотические бактерии в достаточном количестве, что подтверждает их полезные свойства для здоровья. Это важно для потребителей, так как позволяет им делать осознанный выбор при покупке кисломолочных продуктов, ориентируясь на их пробиотическую ценность.
Советы
СОВЕТ №1
Перед началом исследования ознакомьтесь с основными типами кисломолочных продуктов и их составом. Это поможет вам лучше понять, какие именно живые бактерии могут присутствовать в каждом продукте и как они влияют на здоровье.
СОВЕТ №2
При проведении экспериментов обязательно используйте стерильные инструменты и посуды, чтобы избежать загрязнения образцов. Это обеспечит точность ваших результатов и достоверность выводов.
СОВЕТ №3
Не забывайте документировать все этапы вашего исследования. Ведение подробного журнала поможет вам отслеживать изменения и результаты, а также упростит процесс подготовки к презентации.
СОВЕТ №4
При подготовке к презентации постарайтесь визуализировать данные с помощью графиков и диаграмм. Это сделает вашу работу более наглядной и понятной для аудитории, а также поможет подчеркнуть важные выводы вашего исследования.



































































